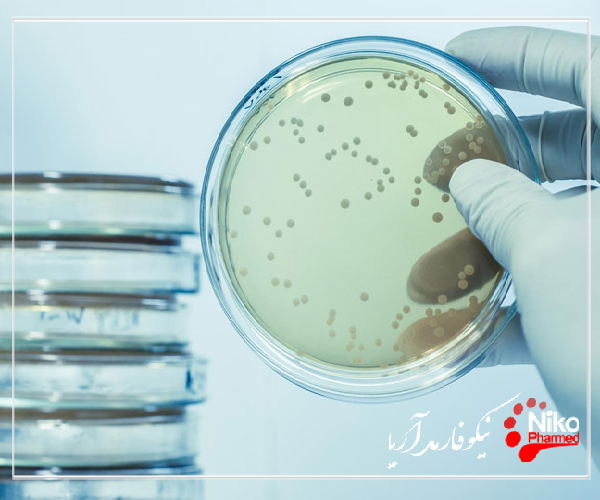
بررسی خاصیت ضد میکروبی به روش انتشار دیسک m/بررسی خاصیت ضد میکروبی به روش انتشار دیسک

بررسی خاصیت ضد میکروبی به روش انتشار دیسک
بررسی خاصیت ضد میکروبی به روش انتشار دیسک؛ روش انتشار دیسک یکی از انعطاف پذیرترین روش های تست حساسیت از نظر عوامل ضد میکروبی قابل آزمایش است. این روش شامل قرار دادن دیسک های کاغذی اشباع شده با عوامل ضد میکروبی بر روی چمنی از باکتری های کاشته شده روی سطح یک محیط آگار، انکوباسیون صفحه در طول شب و اندازه گیری وجود یا عدم وجود یک منطقه بازدارندگی در اطراف دیسک ها است
برای کسب اطلاعات بیشتر و دریافت خدمات با ما تماس بگیرید.
در سال های اخیر، علاقه فزاینده ای به تحقیق و توسعه عوامل ضد میکروبی جدید از منابع مختلف برای مبارزه با مقاومت میکروبی وجود داشته است. بنابراین، توجه بیشتری به روش های غربالگری و ارزیابی فعالیت ضد میکروبی شده است. چندین روش زیست سنجی مانند دیسک دیفیوژن، انتشار چاه و رقت براث یا آگار به خوبی شناخته شده و معمولاً مورد استفاده قرار میگیرند، اما روشهای دیگر مانند روشهای فلوسیتوفلوئوروومتری و بیولومینسنت به طور گسترده مورد استفاده قرار نمیگیرند، زیرا نیاز به تجهیزات مشخص و ارزیابی بیشتر برای تکرارپذیری و استانداردسازی دارند، حتی اگر آنها می توانند نتایج سریعی از اثرات عامل ضد میکروبی و درک بهتری از تأثیر آنها بر زنده ماندن و آسیب سلولی وارد شده به میکروارگانیسم آزمایش شده ارائه دهند. در این مقاله مروری، فهرست جامعی از روشهای تست حساسیت ضد میکروبی در شرایط آزمایشگاهی و اطلاعات دقیق در مورد مزایا و محدودیتهای آنها گزارش شده است.
روش انتشار دیسک
بررسی خاصیت ضد میکروبی بهه روش انتشار دیسک (DDM) به عنوان یک روش انتشار آگار (ADM) طبقه بندی می شود، چرا که عصاره گیاهی که باید آزمایش شود از مخزن خود از طریق محیط آگار بذر شده با میکروارگانیسم آزمایش پخش می شود. به طور کلی، مخزن یک دیسک کاغذ صافی است که در بالای سطح آگار قرار می گیرد. اگر عصاره های گیاهی آزمایش شده یا ترکیبات جدا شده از نظر میکروبیولوژیکی فعال باشند، پس از انکوباسیون، یک ناحیه بازدارنده در اطراف دیسک کاغذ صافی ایجاد می شود.
قطر ناحیه مهار به درستی قدرت ضد میکروبی عصاره های گیاهی یا ترکیبات فردی را توصیف می کند. لازم به ذکر است که DDM روش مناسبی برای عصاره های چربی دوست (به عنوان مثال EOs) نمی باشد زیرا انتشار EO نامحلول در آب و ترکیبات آن از دیسک کاغذ صافی به محیط آگار ناکافی است. بنابراین، EO ها نتایج منفی یا مناطق بازدارندگی کوچکتری با DDM نسبت به سایر آزمایش ها، مانند BDM.13 می دهند.
تست انتشار دیسک (همچنین به عنوان تست انتشار آگار، تست کربی بائر، تست حساسیت آنتی بیوتیکی انتشار دیسک، تست حساسیت آنتی بیوتیکی انتشار دیسک و تست KB نیز شناخته می شود) یک سنجش میکروبیولوژیکی مبتنی بر کشت است که در آزمایشگاه های تشخیصی و کشف دارو استفاده می شود.
در آزمایشگاه های تشخیصی، این روش برای تعیین حساسیت باکتری های جدا شده از عفونت بیمار به آنتی بیوتیک های تایید شده بالینی استفاده می شود. این به پزشکان اجازه می دهد تا مناسب ترین درمان آنتی بیوتیکی را تجویز کنند.
در آزمایشگاههای کشف دارو، به ویژه آزمایشگاه های اکتشاف زیستی، این سنجش برای غربالگری مواد بیولوژیکی (مانند عصارههای گیاهی، آبگوشتهای تخمیر باکتریایی) و کاندیدهای دارویی برای فعالیت ضد باکتریایی استفاده میشود. هنگام اکتشاف زیستی، سنجش را می توان با سویه های جفتی از باکتری ها برای دستیابی به حذف تکثیر و شناسایی موقت مکانیسم اثر ضد باکتریایی انجام داد.
در آزمایشگاه های تشخیصی، آزمایش با تلقیح سطح صفحه آگار با باکتری های جدا شده از عفونت بیمار انجام می شود. سپس دیسک های کاغذی دارای آنتی بیوتیک روی آگار اعمال می شود و صفحه انکوبه می شود.
اگر یک آنتی بیوتیک رشد باکتری را متوقف کند یا باکتری را از بین ببرد، ناحیه ای در اطراف دیسک وجود خواهد داشت که باکتری به اندازه کافی رشد نکرده است که قابل مشاهده باشد. به این منطقه بازداری می گویند.
سپس می توان با مقایسه اندازه این مناطق بازدارندگی با پایگاههای اطلاعاتی در مورد باکتریهای حساس به آنتی بیوتیک، نسبتاً حساس و مقاوم به آنتی بیوتیک، حساسیت جدایه باکتری به هر آنتی بیوتیک را به صورت نیمه کمی تعیین کرد. به این ترتیب می توان مناسب ترین آنتی بیوتیک را برای درمان عفونت بیمار شناسایی کرد
اگرچه آزمایش انتشار دیسک نمی تواند برای افتراق فعالیت باکتریواستاتیک و باکتری کشی استفاده شود، اما نسبت به سایر روش های تست حساسیت مانند رقت کردن براث دست و پا گیرتر است.
مقالات بیشتر:
پایداری تسریع شده محصولات پزشکی
بررسی خاصیت ضد میکروبی به روش MIC و MBC
در آزمایشگاههای کشف دارو، آزمایش انتشار دیسک کمی متفاوت از آزمایشگاههای تشخیصی انجام میشود. در این تنظیمات، این سویه باکتری نیست که باید مشخص شود، بلکه یک عصاره آزمایشی (به عنوان مثال یک گیاه یا عصاره میکروبی) است.
بنابراین صفحه آگار با یک سویه باکتریایی با فنوتیپ شناخته شده (اغلب سویه ATCC یا NCTC) تلقیح می شود و دیسک های حاوی عصاره آزمایش روی سطح اعمال می شود.
اندازه منطقه بازدارندگی را نمی توان به عنوان یک معیار نیمه کمی برای قدرت ضد باکتری استفاده کرد زیرا عصاره های مختلف حاوی مولکول هایی با ویژگی های انتشار مختلف (اندازه های مولکولی مختلف، آب دوستی و غیره) هستند.
با این وجود، می توان از اندازه های ناحیه بازدارنده به منظور حذف مجدد آن ها استفاده کرد. این کار با آزمایش هر عصاره در برابر سویه های جفت باکتری (مانند سویههای حساس و مقاوم به استرپتومایسین برای شناسایی عصارههای حاوی استرپتومایسین) به دست میآید. سویههای جفتی (مانند گونههای وحشی و سویههای دارای بیان بیش از حد هدف) نیز میتوانند برای شناسایی مکانیسم اثر ضد باکتریایی استفاده شوند.
آنتی بیوتیک ها و نگهدارنده ها
روش های خودکار
روشهای انتشار دیسک و رقیق سازی براث را میتوان با استفاده از تحلیلگرهای تصویر برای خواندن مناطق و یا دستگاههای کدورت خوان نیمه خودکار کرد، اینها نتیجه عینی تری به شما می دهند و می توانند با نرم افزاری برای تفسیر خودکار نتایج ارائه شوند.
سیستم های خودکار که به طور گسترده مورد استفاده قرار می گیرند، معمولاً شناسایی را با تست حساسیت ترکیب می کنند. استفاده از ابزار دقیق میتواند خواندن نقاط پایانی را استاندارد کند و اغلب نتایج تست حساسیت را در مدت زمان کوتاه تری نسبت به قرائتهای دستی ایجاد میکند، زیرا سیستم های تشخیص نوری حساس امکان تشخیص تغییرات ظریف در رشد باکتری ها را فراهم میکنند.
با روش های خودکار، کل آزمون تنظیم می شود و به طور خودکار خوانده می شود، نه تنها حجم کار کاهش می یابد، بلکه نتیجه نیز کمتر ذهنی و قابل تکرار است. نتایج معمولاً سریع تر هستند، با نتایج یک روزه ممکن است زیرا ابزارها با خواندن مداوم و نتایج پایه بر روی سینتیک رشد، رشد را نظارت میکنند.
در حالی که سیستم های خودکار مزایای زیادی دارند، میتوانند از نظر انتخاب آنتی بیوتیکهای موجود انعطاف پذیری کمتری داشته باشند، هزینه های مصرفی معمولاً بالاتر است و هزینه های تجهیزات باید با خرید مستقیم، اجاره یا قراردادهای اجاره معرف، همراه با خدمات و نگهداری تامین شود.
هم برای خوانندگان ناحیه نیمه خودکار و هم برای سیستم های شناسایی و حساسیت کاملاً خودکار، داده های جمع آوری شده را میتوان توسط سیستم های نرم افزاری خبره یا هوشمند برای تفسیر ارزیابی کرد، نتایج غیرعادی غیرعادی را برجسته کرد، آنتی بیوتیک های احتمالی دیگر را پیشنهاد کرد و می توان آن را به مدیریت اطلاعات آزمایشگاهی دیگر صادر کرد.
استفاده از روش های ژنوتیپی برای تشخیص ژن های مقاومت ضد میکروبی به عنوان راهی برای افزایش سرعت و دقت تست حساسیت ترویج شده است. روشهایی که از ژنومیک مقایسه ای، پروب های ژنتیکی، ریز آرایه ها، تکنیک های تقویت اسید نوکلئیک (مانند واکنش زنجیرهای پلیمراز (PCR)) و توالی یابی DNA استفاده میکنند، قادر به افزایش حساسیت، ویژگی و سرعت در تشخیص ژن های مقاومت شناخته شده خاص هستند.





